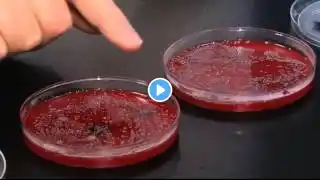
ภาพตัวอย่างวิดีโอ

Germs, bacteria, and diseases living on your phone
Many of us take our phones with us wherever we go, including the bathroom. We were curious how this affected the phones, and if there could be any bacteria, pathogens, or anything else on them. We sampled 19 phones for bacteria and brought them to Dr. Susan Whittier — Director of Microbiology at the NewYork-Presbyterian/Columbia University Medical Center. Here are the results. Disclaimer: Our results are from a small, selective sample and do not necessarily apply to the general population. Read more: http://www.techinsider.io/ FACEBOOK: / techinsider TWITTER: / businessinsider INSTAGRAM: / businessinsider TUMBLR: / businessinsider